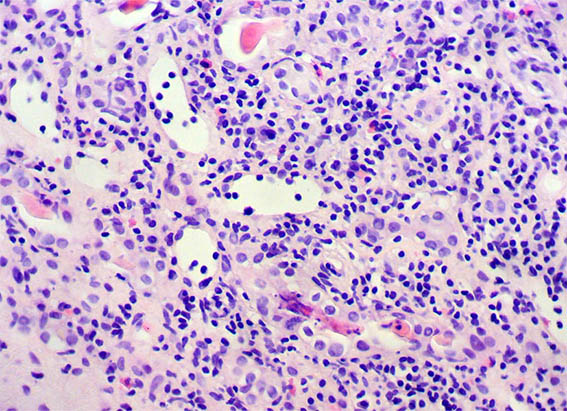

|
|
CASO
203 (enero de 2023)
Datos clínicos:
Un hombre de 35 años es diagnosticado de infección por VIH en 2003. Se inició tratamiento con zidovudina, lamivudina e indinavir. En 2005 presenta episodio de gastroenteritis, con diarrea, vomito y deshidratación que duró una semana. Hubo elevación de la creatinina sérica hasta 4,3 mg/dL, BUN 57 mg/dL. Carga viral en sangre: indetectable; conteo de C4d: normal. En el uroanálisis hay proteinuria de 100 mg/dL, eritrocitos en el sedimento: 5-7 por campo de gran aumento (CGA) y leucocitos: 4-5/CGA; no describen cilindros.
Diez días después de teminar el cuadro gastrointestinal el paciente continúa con edema de miembros inferiores, ya sin otra sintomatología, y persiste con creatinina alta: 3,6 mg/dL, por lo que se hace biopsia renal.

Figura 1. Tricrómico de Masson, X400. Glomérulos normales; hay fibrosis periglomerular.

Figura 2. Plata-metenamina, X400. Glomérulo con características normales.
Figura 3.
H&E, X400. Zonas con marcada inflamación intersticial y daño tubular.

Figura 4. H&E, X100.

Figura 5. Tricrómico de Masson, X100. Observe lo que hay en algunos túbulos, los cuales están muy dilatados.

Figura 6. Plata-metenamina, X200.

Figura 7. H&E, X200.

Figura 8. H&E, X400.

Figura 9. H&E, X400.

Figura 10. Tricrómico de Masson, X400.

Figura 11. Plata-metenamina, X400.
Inmunofluorescencia directa para IgA, IgG, IgM, C3, C1q, kappa y lambda: Negativas.
¿Cuál es su diagnóstico?
Ver
diagnóstico y discusión
[Arriba]
|
|